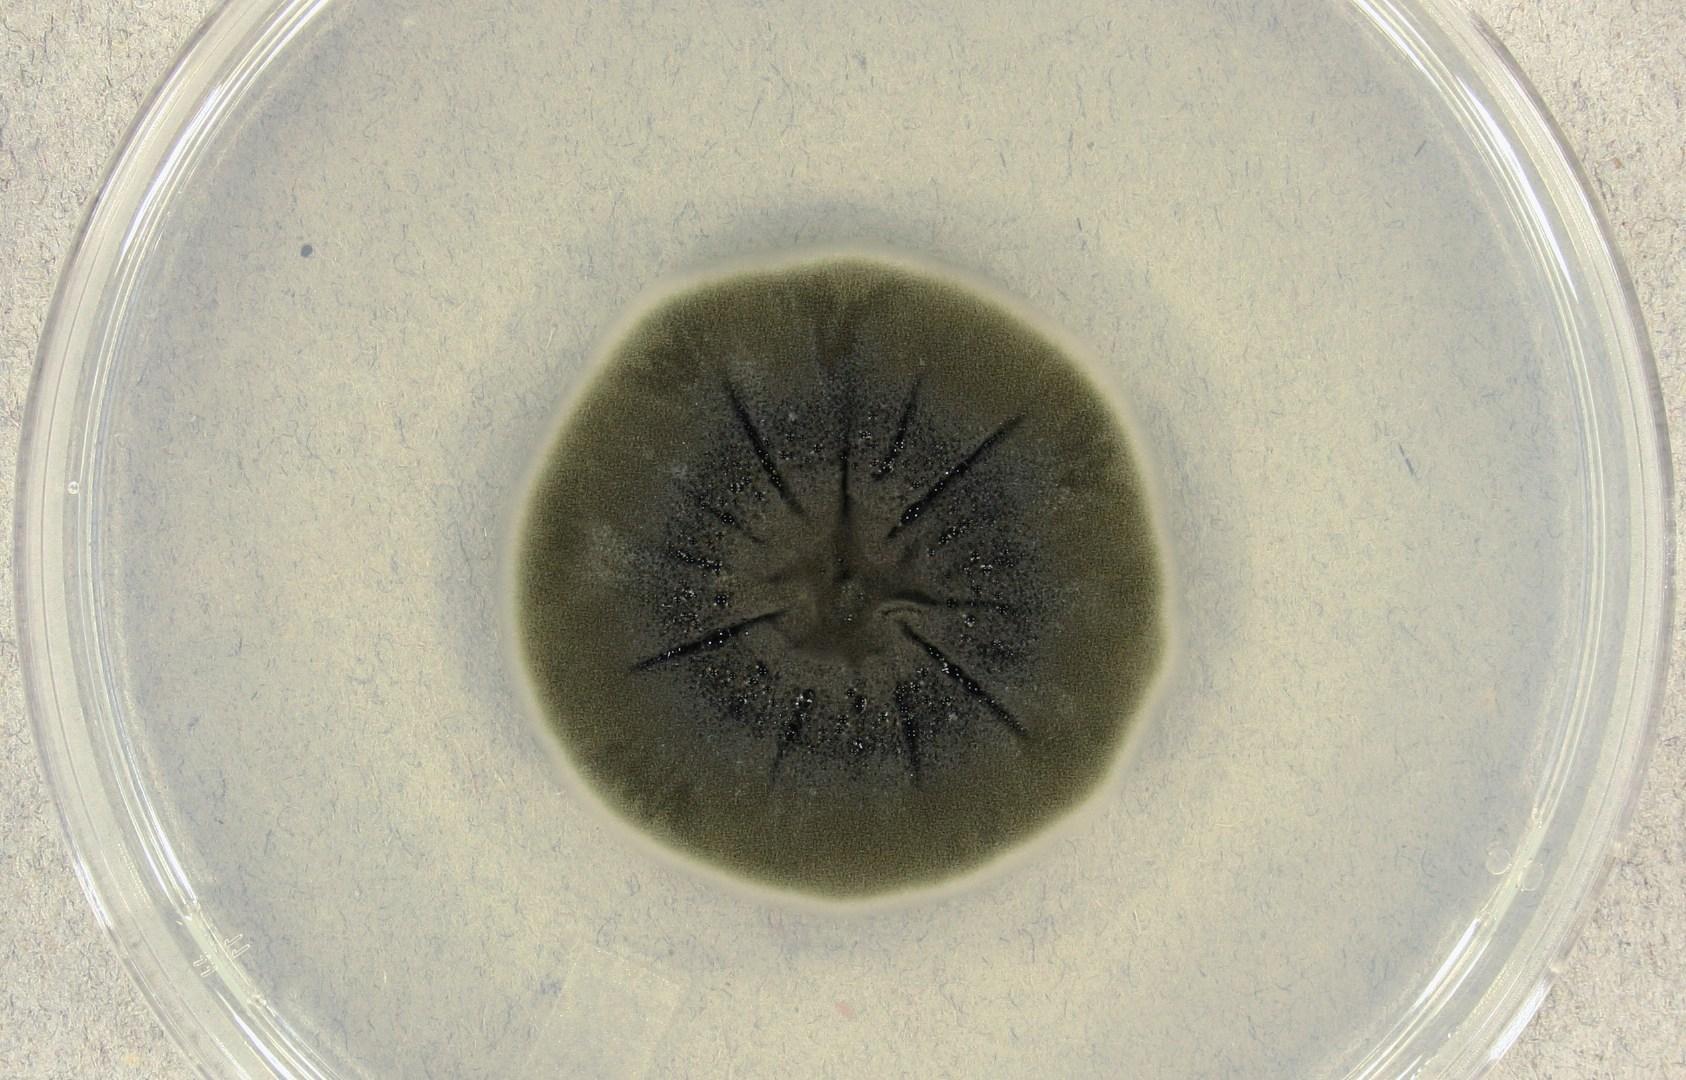

أفريقيا برس – موريتانيا. يظل انفجار المفاعل رقم 4 في محطة تشرنوبل للطاقة النووية بالقرب من مدينة بريبيات بأوكرانيا في 26 أبريل/نيسان 1986 أسوأ كارثة نووية في تاريخ البشرية، إذ تسببت في خلق منطقة حظر بقطر 30 كيلومترًا؛ ظلت حتى اللحظة منطقة مهجورة لأن مستويات الإشعاع لا تزال مرتفعة.
ومع ذلك، اكتشف العلماء داخل هذه المنطقة كائنا حيا بدا أنه نجا من هذه البيئة العدائية للغاية، وهو فطر أسود يسمى “كلادوسبوريوم سفايروسبيرموم”، وبشكل خاص لاحظ العلماء بقعًا للفطر على جدران المفاعل رقم 4، بل كانت توجه خيوطها مثلما يمدّ النبات جذوره نحو الغرافيت المشع بسبب الكارثة.
وقد أظهرت أبحاث أخرى أجريت في كلية ألبرت أينشتاين للطب أن 3 فطريات (منها كلادوسبوريوم سفايروسبيرموم) زادت كتلتها الحيوية بشكل أسرع في بيئة كان فيها مستوى الإشعاع أعلى 500 مرة من البيئة الطبيعية.
تتغذى على الإشعاع
في البداية ظن العلماء أن تلك الخيوط تتفرع باحثة عن الكربون، لكن ثبت خطأ هذا الادعاء، وخلصت النتائج إلى أن تلك الفطريات تنمو في اتجاه مصدر الإشعاع المؤين بيتا وغاما.
وفي حين أن هناك العديد من حالات الكائنات الحية التي يمكن أن تعيش في ظروف قاسية مثل محطات الطاقة المشعة، فإن الفطريات المشعة هذه لم تكن تنمو “رغم الإشعاع” مثل تلك الكائنات، بل “بسبب الإشعاع”، إذ أصبح مصدر الطاقة الخاص بها، بحسب الدراسة التي نشرها فريق كلية ألبرت أينشتين للطب في دورية “بلوس وان”.
وقد تبين للعلماء أن تلك الفطريات تحول الإشعاع المؤين إلى طاقة كيميائية لتغذية نموها، وهي العملية التي تسهلها صبغة الميلانين في خلاياها.
تحتوي تلك الفطريات المشعة على الميلانين، وهو الصبغة ذاتها الموجودة في الجلد البشري. ويلتقط الميلانين الإشعاع المؤين ويحوله إلى طاقة كيميائية، على غرار الطريقة التي يحول بها الكلوروفيل في النباتات ضوء الشمس إلى طاقة أثناء عملية التمثيل الضوئي.
أفق للتطبيق العلمي
ورغم أن هذه العملية ليست مطابقة لعملية التمثيل الضوئي، فإنها تخدم غرضًا مماثلًا وتحول الطاقة من البيئة لدعم نمو الكائن الحي. فتحت هذه الظاهرة، التي تسمى التمثيل الإشعاعي، آفاقًا مثيرة في أبحاث الكيمياء الحيوية والإشعاع.
ويعتقد العلماء حاليا أنه يمكن للفطريات المشعة أن توفر بديلًا طبيعيًّا أكثر أمانًا لاحتواء مستويات الإشعاع في المناطق الملوثة وخفضها. وتبحث فرق بحثية عدة في تطبيقات أخرى، وخاصة في مجال استكشاف الفضاء، إذ إن البيئة القاسية والمملوءة بالإشعاع في الفضاء من أهم التحديات التي تواجه البعثات الطويلة الأجل إلى المريخ وما بعده.
وقد تم بالفعل إرسال كلادوسبوريام سفايروسبيرمام إلى محطة الفضاء الدولية لإجراء تجارب لتحديد ما إذا كانت قدرتها الفريدة على تحمل الإشعاع يمكن أن تحمي رواد الفضاء من الإشعاع الكوني، وكانت النتائج الأولية واعدة.
يمكنكم متابعة المزيد من أخبار و تحليلات عن موريتانيا عبر موقع أفريقيا برس